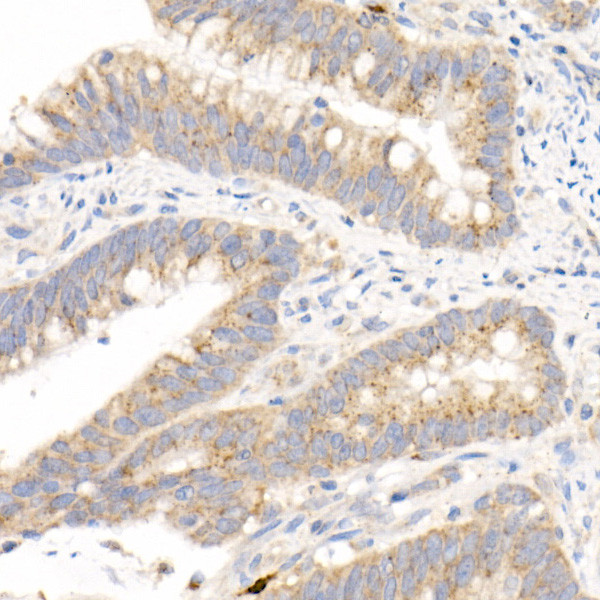
MMP3 Antibody in Immunohistochemistry (Paraffin) (IHC (P))

Search
Invitrogen
MMP3 Recombinant Rabbit Monoclonal Antibody (6K2S2)
{{$productOrderCtrl.translations['antibody.pdp.commerceCard.promotion.promotions']}}
{{$productOrderCtrl.translations['antibody.pdp.commerceCard.promotion.viewpromo']}}
{{$productOrderCtrl.translations['antibody.pdp.commerceCard.promotion.promocode']}}: {{promo.promoCode}} {{promo.promoTitle}} {{promo.promoDescription}}. {{$productOrderCtrl.translations['antibody.pdp.commerceCard.promotion.learnmore']}}
图: 1 / 4
MMP3 Antibody (MA5-51191) in IHC (P)




Please note: We are reviewing Western blot images included in the antibody testing data in our catalog, including those provided by third parties. Unless expressly labeled or annotated as “raw-unedited”, Western blot images included in the antibody testing data in our catalog may have been edited, optimized or otherwise adjusted for presentation.
产品信息
MA5-51191
种属反应
宿主/亚型
Expression System
分类
类型
克隆号
抗原
偶联物
形式
浓度
规格
纯化类型
保存液
内含物
保存条件
运输条件
RRID
产品详细信息
Immunogen sequence: VRKIDAAISD KEKNKTYFFV EDKYWRFDEK RNSMEPGFPK QIAEDFPGID SKIDAVFEEF GFFYFFTGSS QLEFDPNAKK VTHTLKSNSW LNC
靶标信息
MMP3 (stromelysin-1) belongs to the peptidase M10A subfamily. It is secreted in its pro-protein form, and is activated by extracellular proteinase cleavage. MMP3 is capable of binding to zinc and calcium ions, and has metallo-endopeptidase activity. The active enzyme degrades collagen, gelatin, fibronectin, and laminin. It is involved in normal cellular processes such as wound repair and tissue remodeling. Mutations in the gene can result in coronary heart disease 6.
仅用于科研。不用于诊断过程。未经明确授权不得转售。
篇参考文献 (0)
生物信息学
蛋白别名: EC 3.4.24.17; EMS-2; matrix metallo protease; matrix metalloproteinase 3; Matrix metalloproteinase-3; MMP; MMP-3; MMPs; progelatinase; SL-1; stromelysin 1; Stromelysin-1; Stromelysin1; Transin-1; Transin1
基因别名: MMP3; SLN-1; SLN1; STMY1; STR-1; Str1
UniProt ID: (Mouse) P28862
Entrez Gene ID: (Mouse) 17392, (Rat) 171045